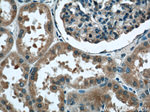
TBC1D22A Antibody in Immunohistochemistry (Paraffin) (IHC (P))

Search
Proteintech
TBC1D22A Polyclonal Antibody
{{$productOrderCtrl.translations['antibody.pdp.commerceCard.promotion.promotions']}}
{{$productOrderCtrl.translations['antibody.pdp.commerceCard.promotion.viewpromo']}}
{{$productOrderCtrl.translations['antibody.pdp.commerceCard.promotion.promocode']}}: {{promo.promoCode}} {{promo.promoTitle}} {{promo.promoDescription}}. {{$productOrderCtrl.translations['antibody.pdp.commerceCard.promotion.learnmore']}}
产品信息
18332-1-AP
种属反应
宿主/亚型
分类
类型
抗原
偶联物
形式
浓度
规格
纯化类型
保存液
内含物
保存条件
运输条件
产品详细信息
Immunogen sequence: MASDGARKQ FWKRSNSKLP GSIQHVYGAQ HPPFDPLLHG TLLRSTAKMP TTPVKAKRVS TFQEFESNTS DAWDAGEDDD ELLAMAAESL NSKVVMETAN RVLRNHSQRQ GRPTLQEGPG LQQKPRPEAE PPSPPSGDLR LVKSVSESHT SCPAESASDA APLQRSQSLP HSATVTLGGT SDPSTLSSSA LSEREASRLD KFKQLLAGPN TDLEELRRLS WSGIPKPVRP MTWKLLSGYL PANVDRRPAT LQRKQKEYFA FIEHYYDSRN DEVHQDTYRQ IHIDIPRMSP EALILQPKVT EIFERILFIW AIRHPASGYV QGINDLVTPF FVVFICEYIE AEEVDTVDVS CVPAEVLCNI EADTYWCMSK LLDGIQDNYT FAQPGIQMKV KMLEELVSRI DEQVHRHLDQ HEVRYLQFAF RWMNNLLMRE VPLRCTIRLW DTYQSEPDGF SHFHLYVCAA FLVRWRKEIL EEKDFQELLL FLQNLPTAHW DDEDISLLLA EAYRLKFAFA DAPNHYKK (1-517 aa encoded by BC001292)
靶标信息
TBC1D22A (TBC1 domain family, member 22A), also known as C22orf4, is a 517 amino acid protein that contains one Rab-GAP TBC domain and is thought to function as a GTPase-activating protein for Rab family members. Multiple isoforms of TBC1D22A exist due to alternative splicing events. The gene encoding TBC1D22A maps to human chromosome 22, which houses over 500 genes and is the second smallest human chromosome. Mutations in several of the genes that map to chromosome 22 are involved in the development of Phelan-McDermid syndrome, neurofibromatosis type 2, autism and schizophrenia. Additionally, translocations between chromosomes 9 and 22 may lead to the formation of the Philadelphia chromosome and the subsequent production of the novel fusion protein BCR-Abl, a potent cell proliferation activator found in several types of leukemias.
仅用于科研。不用于诊断过程。未经明确授权不得转售。
篇参考文献 (0)
生物信息学
蛋白别名: C22orf4; putative GTPase activator; TBC1 domain family member 22A; TBC1 domain family, member 22a; unnamed protein product
基因别名: BC023106; C22orf4; D15Ertd781e; HSC79E021; RGD1306588; TBC1D22A
UniProt ID: (Human) Q8WUA7, (Mouse) Q8R5A6
Entrez Gene ID: (Human) 25771, (Rat) 689443, (Mouse) 223754